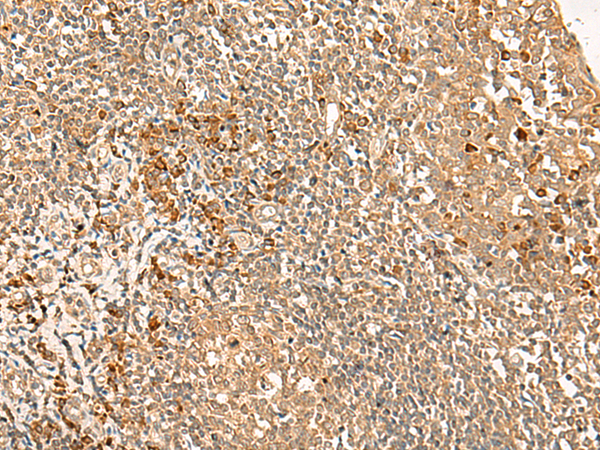
一抗

|
Background: |
This gene was identified upon genomic analysis of a gene-dense region at human chromosome 12p13. It appears to be mainly expressed in the brain; however, its function is not known. Alternatively spliced transcript variants encoding different isoforms have been identified. |
|
Applications: |
ELISA, IHC |
|
Name of antibody: |
GPR162 |
|
Immunogen: |
Synthetic peptide of human GPR162 |
|
Full name: |
G protein-coupled receptor 162 |
|
Synonyms: |
A-2; GRCA |
|
SwissProt: |
Q16538 |
|
ELISA Recommended dilution: |
5000-10000 |
|
IHC positive control: |
Human tonsil |
|
IHC Recommend dilution: |
40-200 |

 購物車
購物車 幫助
幫助
 021-54845833/15800441009
021-54845833/15800441009